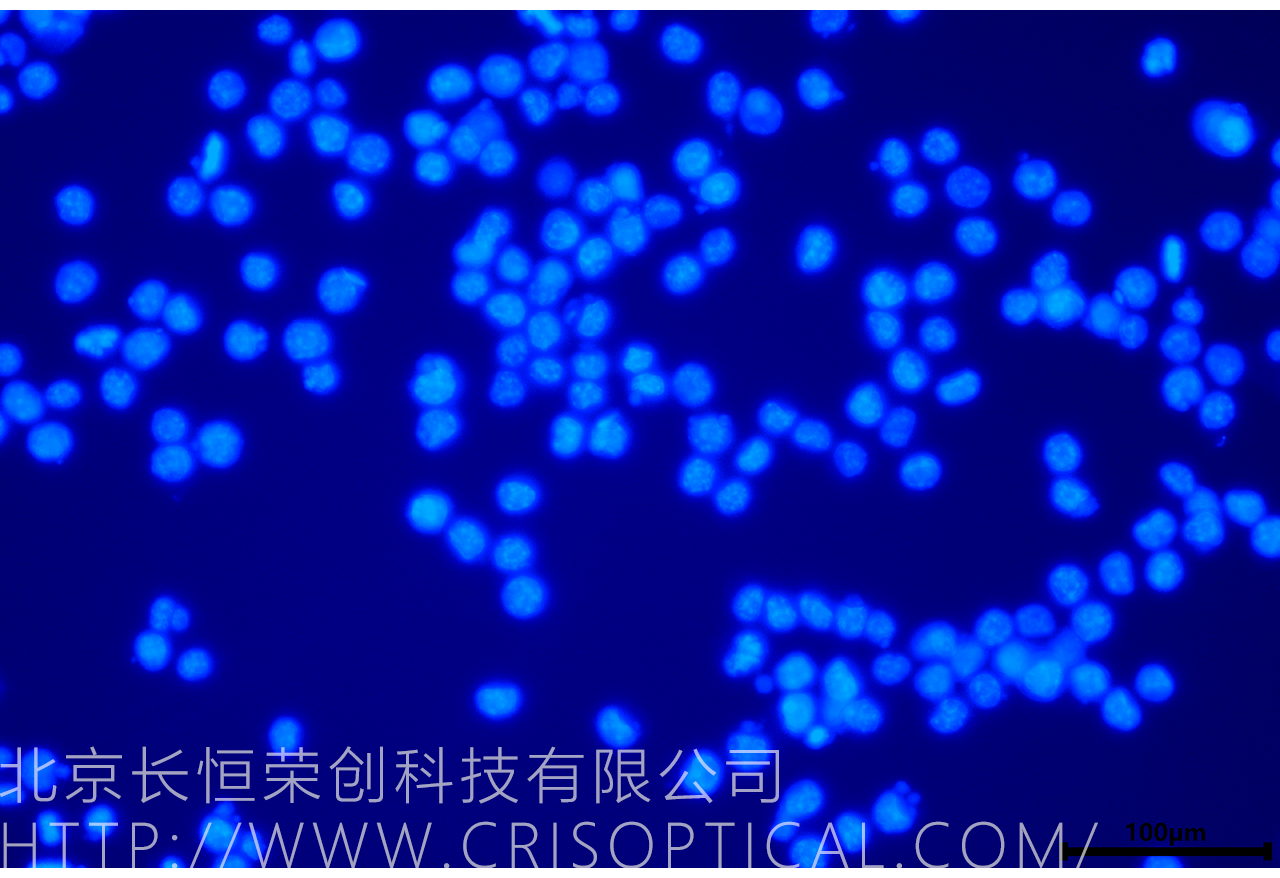

一、實驗用途
細胞染料在生命科學研究、醫(yī)學診斷、藥物發(fā)現(xiàn)和生物工程等多個領域中發(fā)揮著關鍵作用。
?
1. 生命科學研究
細胞生物學: 細胞染料用于研究細胞的結構和功能,例如標記和追蹤特定蛋白質(zhì)或細胞器,以解析細胞的亞細胞結構。
免疫細胞化學: 用于檢測和分析細胞表面蛋白質(zhì)的表達,幫助了解細胞信號傳導和免疫細胞亞群的特性。
細胞凋亡研究: 染色劑可以用于檢測和定量細胞凋亡,幫助研究細胞死亡機制。
細胞遷移和侵襲研究: 細胞染料可用于研究癌癥細胞的遷移和侵襲能力,揭示腫瘤轉移的機制。
?
2. 醫(yī)學診斷
細胞學檢查: 在細胞學檢查中,細胞染料用于染色細胞,以幫助診斷和分析細胞樣本,如血液涂片和細胞核的細胞。
流式細胞術: 細胞染料被廣泛應用于流式細胞儀,用于分析和分類細胞懸浮物。
組織學檢查: 細胞染料也用于組織學檢查,以幫助診斷組織樣本,如腫瘤標記和免疫組織化學。
?
3. 藥物發(fā)現(xiàn)和藥理學
高通量篩選: 細胞染料在高通量篩選中用于評估藥物對細胞的影響,加速新藥物的發(fā)現(xiàn)和開發(fā)。
藥物轉運研究: 細胞染料可用于研究藥物的轉運機制和細胞內(nèi)分布。
?
4. 生物工程和生物制造
細胞工程: 細胞染料在生物工程中用于標記和篩選改造的細胞,以增強生物制造過程。
蛋白質(zhì)表達監(jiān)測: 用于監(jiān)測重組蛋白質(zhì)的表達和純化,以提高蛋白質(zhì)制備的效率。
?
5. 神經(jīng)科學
神經(jīng)元成像: 細胞染料可用于標記和追蹤神經(jīng)元,幫助研究神經(jīng)元網(wǎng)絡和神經(jīng)活動。
突觸研究: 用于研究突觸結構和功能,揭示神經(jīng)傳遞的機制。
?
6. 環(huán)境監(jiān)測
水質(zhì)監(jiān)測: 細胞染料可用于檢測和監(jiān)測水體中的微生物和生物污染,評估水質(zhì)和生態(tài)健康。
生態(tài)毒理學研究: 用于研究環(huán)境毒物對水生生物和生態(tài)系統(tǒng)的影響。
?
7. 科學教育和科普
教學實驗: 細胞染料的使用有助于生物學課程中的實驗教學,幫助學生理解細胞結構和功能。
科學傳播: 細胞染料的可視化效果有助于科普和科學傳播,向公眾介紹生命科學的基本原理。
二、案例圖片

三、儀器配置



